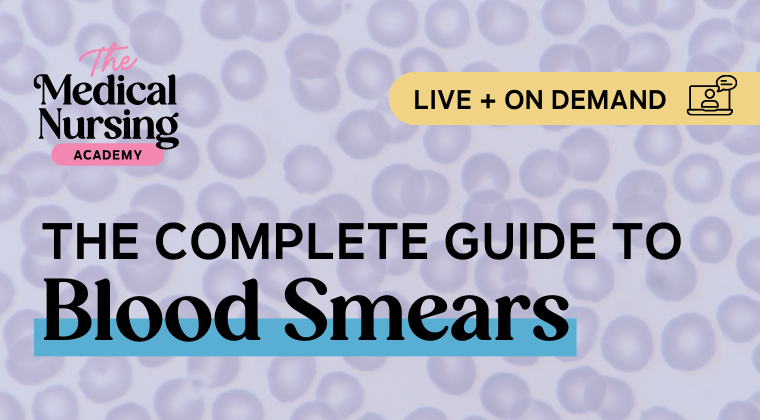

Education, Support and Courses for Veterinary Nurses
Veterinary nurses perform best when they are supported, motivated, and empowered, and are able to do more in practice.
Three NEW Ways to Learn!
-
The Newest Webinar: Blood Smears Made Easy for VNs
Join me live on February 26th (or on-demand via the recording) for this session on interpreting blood smears!
-

NEW: Use Evidence-Based Vet Nursing to give Better Care
Join me for a live evidence-based nursing session help you improve care and protocols in your own clinics!
-

Access the ENTIRE Library by Joining the Club
Sign up for the Library Club NOW and get monthly access to ALL webinars!
The Most Comprehensive Internal Medicine Education Library You’ll Find
Join The Medical Nursing Academy (grab a library club membership!) and never miss out on the latest educational webinars and live sessions.
I help student and registered veterinary nurses/technicians who feel stuck in their careers feel more confident, speak up for their patients, and give better care.
There are plenty of CPD courses out there - but the framework I use is different. It doesn’t just bombard you with information about complicated diseases - it gives you the tools to turn that knowledge into nursing care aimed at making the patient feel better.
Free Resources
✲
Free Resources ✲
Hi, I’m Laura!
I’m a UK-based RVN and Veterinary Technician Specialist (VTS) in Small Animal Internal Medicine.
I’m on a mission to help veterinary nurses learn more about medical diseases, develop new skills, and provide the best care they can for their patients.
I’m passionate about making medicine less confusing, and showing nurses just how much we can do to care for these patients, as well as sharing hints and tips to make medical nursing easy.
Want more? Check out the Podcast!
Forever free medical nursing CPD delivered each week to help nurses understand complex medical diseases, and give better patient care.
The First On-Demand Medical Nursing Course with Live Case-Based Support
Meet the Foundation Award in Medical Nursing - a 12-month course that helps you go from feeling overwhelmed by complicated conditions to confidently caring for your patients, safe in the knowledge that you’re meeting their exact needs.